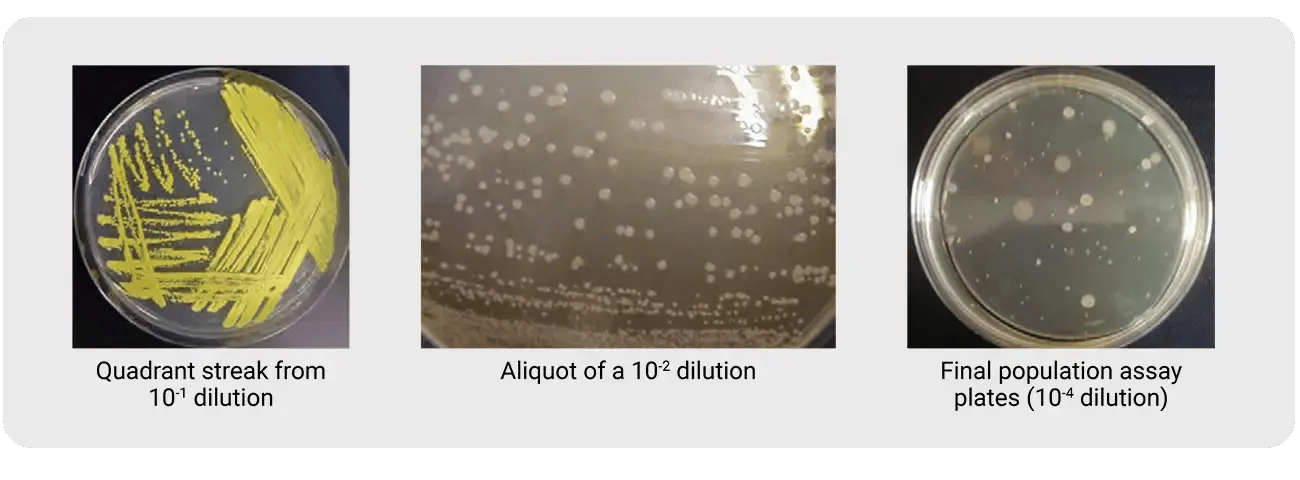
Three agar plate examples for biological indicator purity testing: quadrant streak from 10⁻¹ dilution showing yellow colonies, aliquot of a 10⁻² dilution, and final population assay plate at 10⁻⁴ dilution confirming a single colony type

Biological Indicator Purity Testing: Key Requirements & Best Practices for Users
By Laurent Berliet and Karlin Gardner
Introduction
Biological indicators (BIs) play a critical role in validating and monitoring sterilization processes in the pharmaceutical industry. Because they contain a known and defined population of highly resistant reference microorganisms, BIs provide a direct measure of the lethality of the cycle and are mandatory for qualifying and validating a sterilization or decontamination process.
Due to the importance and criticality of the BI’s role, it is essential for users to perform incoming quality control to ensure the integrity and reliability of these biological indicators before use, even if the BI manufacturer has conducted all necessary studies to ensure the stability of their BIs during storage and shipment. The most well-known and frequently performed controls are population testing and identification of the inoculated organism. A third aspect of this control is the purity test, which is required by several standards, such as USP, Ph. Eur., and EU GMP Annex 1:
USP <1229.5>
Purity
By examination of the colonies derived from the spores on a suitable plate culture medium, determine that there is no evidence of contamination with other microorganisms.
Ph. Eur. 5.1.2
2-2-2 Quality control
Quality control for biological indicators consists of testing for purity, identity and estimation of the number of viable cells.
Purity
Examination of the micro-organisms on a suitable culture medium incubated under appropriate conditions shall not show any evidence of contamination.
EU GMP Annex 1
Sterilization
8.43 The reliability of BIs is important. Suppliers should be qualified and transportation and storage conditions should be controlled in order that BI quality is not compromised. Prior to use of a new batch/lot of BIs, the population, purity and identity of the indicator organism of the batch/lot should be verified. For other critical parameters, e.g. D-value, Z-value, the batch certificate provided by the qualified supplier can normally be used. This control is often the source of confusion and misunderstanding about what users must confirm and how.
This article outlines the importance, methodology, and regulatory considerations of performing a purity test as part of the incoming inspection process, helping users maintain compliance and ensure patient safety.
Standards & References
To understand the purpose of this control and how it should be performed, the notion of purity must be clarified.
1. What should be pure?
ISO 11138-1 specifies all requirements necessary to manufacture and supply a certified biological indicator. A biological indicator has several main components: the inoculated organism, the carrier (e.g., media, paper strip, stainless steel disc), and the primary packaging (e.g., glass ampoules, glassine envelopes).
The purity requirement is specified in ISO -11138-1:
4.2.2 Originating inoculum for suspension
4.2.2.1 the initial Inoculum for each batch of test organism suspension shall be
a) traceable to the reference culture and available through a recognized culture collection, and
b) verified as to its identity and purity
This means purity must be confirmed for the inoculated organism and therefore must be performed on the suspension used by the BI manufacturer to produce the biological indicators. ISO is not restrictive as long as BI performance is not affected. To meet ISO 11138 requirements, Mesa Labs tests the purity of all spore suspension cultures used to inoculate each batch of manufactured -BIs, with a purity acceptance criterion of 0,0001% (1 CFU per 106 indicator organism). This test includes incubation at the opposite temperature (e.g., 30-35°C for Geobacillus stearothermophilus) to detect any mesophilic contaminates. Mesa Labs also confirms the identity of the strain used in all suspensions by a polyphasic approach which includes genetic and phenotypic identification, as well as traceability of the mother crop to a certified culture collection.
This step is crucial for all reputable biological indicator manufacturers to guarantee that the user receives the stated number of spores of the specified strain on the inoculated substrate (as documented on the Certificate of Analysis) and not a mixed population of different organisms. A single well-characterized organism is essential to ensure a consistent and expected challenge to the validated process.
2. What about the entire BI - carrier and packaging?
ISO 11138-1:2017
4.1.1 Quality management systems
A formal quality system (e.g. ISO 13485, GMPs or other national or regional requirements) to cover all operations required by this document shall be established, documented and maintained. In particular, precautions at all stages of production to minimize contamination that would adversely affect the performance of the biological indicator shall be taken.
5.2 Carrier, primary and secondary packaging 5.2.1 The materials of the carrier and the primary and secondary packaging shall not contain any contamination (physical, chemical or microbial) that would adversely affect the performance of the biological indicator.
What does that mean?
In other words, a small amount of contamination, including microbial contamination, could be acceptable, if and only if it does not adversely affect the performance of the BI.
BI manufacturers such as Mesa Labs sterilize all inoculated carriers (paper strips, stainless steel discs) prior to inoculation and control the purity of the suspension used to inoculate the sterile carrier. However, it is still possible for some contamination to occur during production, packaging, or handling. This does not necessarily make the BI non-conforming, as long as its performance characteristics (e.g., resistance) remain as specified on the certificate.
Mesa Labs’ Recommendations
The purpose of the purity test is to confirm that all colonies counted during population testing originate from the same organism. This can be done in conjunction with population control by examining the CFUs on the plate and confirming they are all morphologically identical. Per USP and Ph. Eur., the test must be performed by examining colonies on suitable plate culture medium. EU GMP Annex 1 is more explicit, as it specifies “purity of the indicator organism” (i.e., inoculated organism). To confirm the purity of the inoculated organism, Mesa Labs recommends plating an aliquot of the 10-2 dilution, as indicated in the diagram below, and incubating at the organism’s appropriate temperature (e.g., 55-60°C for G. stearothermophilus or 30-35°C for B. atrophaeus). After incubation, confirm that only one type of colony is present.
Observing the final plates during a population assay may also be sufficient to verify that the population estimate comes from a single type of organism.

Because there is no single prescribed method in the standards, the aliquot may be taken earlier or later in the population procedure. The key requirement is that only one colony type be observed on the plate, as shown in the pictures below.
What Should be Avoided?
Some users interpret “purity” to mean incubating the BI first to obtain vegetative growth before testing. This often involves immersing the strips in TSB for 24 hrs before performing identification. This is problematic as any mesophilic environmental contaminant present can and will begin to grow along with the reference organism. And, if the contaminate has a faster growth rate, it can outgrow the reference organism and lead to an incorrect result. This is common with B. atrophaeus, as even one spore of another mesophilic organism can grow faster than the BI organism and dominate the culture. In such cases, identification might detect the contaminate organism instead of or in addition to B. atrophaeus.
Article Resources
1. Spore News SN004 The Importance of 16S rRNA Bacterial Spore Identification
2. Spore News SN067 Sub-culturing a Positive Biological Indicator for Identification
3. Spore News SN077 Spore News reference review -End User or third part organism Identification and Purity
4. Position Statement -- TS-505 "Contamination" on Biological Indicators (Bls) with Non-liquid Carriers
5. ISO 11138-1:2017 Sterilization of health care products - Biological indicators - Part 1: General requirements
6. ISO 11138-7:2019 Sterilization of health care products biological indicators - Part 7: Guidance for the selection, use and interpretation of results
7. United States Pharmacopeia, General Chapter <1113> Microbial Characterization, Identification, and Strain Typing
8. United States Pharmacopeia, General Chapter <1229.5> Biological Indicators for Sterilization
9. European Pharmacopoeia 5.1.2 Biological indicators and related microbial preparations
10. European Commission. (2022). The rules governing medicinal products in the European Union, Volume 4: EU guidelines for good manufacturing practice for medicinal products for human and veterinary use. Annex 1: Manufacture of sterile medicinal products
SN095-V1